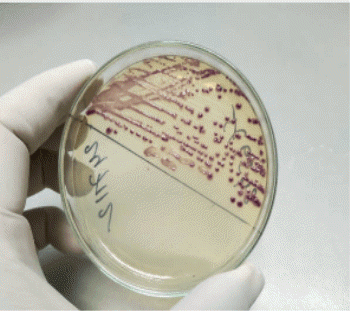
패혈증

티스토리 뷰
여름철 바다나 갯벌에서 활동할 때 반드시 알아야 할 비브리오패혈증에 대해 자세히 알아보겠습니다. 이 질병은 치사율이 높아 각별한 주의가 필요한 감염병입니다.

비브리오패혈증이란?
비브리오패혈증은 비브리오 불니피쿠스(Vibrio vulnificus) 세균에 의해 발생하는 급성 패혈성 질환입니다. 주로 바닷물이나 갯벌, 어패류를 통해 감염되며, 감염 후 24-48시간 내에 급속도로 진행되어 생명을 위협할 수 있습니다.
이 세균은 수온이 18도 이상인 해수에서 번식하며, 특히 7월부터 9월 사이 고수온기에 가장 활발하게 증식합니다.
감염 경로와 고위험군
주요 감염 경로
상처 감염: 피부에 상처가 있는 상태에서 오염된 바닷물이나 갯벌에 노출될 때 세균이 상처를 통해 침입합니다.
경구 감염: 생굴, 생새우, 생게 등 날것의 어패류를 섭취할 때 소화기를 통해 감염됩니다.
고위험군
- 간 질환자 (간경화, B형 간염 등)
- 당뇨병 환자
- 알코올 중독자
- 면역저하 환자
- 만성신부전 환자
이러한 기저질환이 있는 분들은 치사율이 50% 이상에 달하므로 더욱 각별한 주의가 필요합니다.
"이 포스팅은 쿠팡 파트너스 활동의 일환으로, 이에 따른 일정액의 수수료를 제공받습니다."
비브리오패혈증 증상
초기 증상 (감염 후 12-24시간)
- 갑작스러운 고열 (38도 이상)
- 오한과 전신 근육통
- 구토와 설사
- 복통
진행 단계 증상 (감염 후 24-48시간)
- 피부 병변: 상처 부위가 빨갛게 부어오르며 수포가 생깁니다
- 조직 괴사: 감염 부위 조직이 검게 변하면서 썩어들어갑니다
- 혈압 저하
- 의식 저하
중요: 초기 증상이 나타나면 즉시 병원을 방문해야 합니다. 시간이 지날수록 치료가 어려워지고 절단이나 사망에 이를 수 있습니다.
진단과 치료
진단 방법
- 혈액 배양 검사: 혈액에서 비브리오균 검출
- 상처 배양 검사: 상처 분비물에서 균 확인
- 임상 증상과 역학적 조사: 바다 활동 이력, 어패류 섭취 이력 확인
치료법
항생제 치료: 독시사이클린과 세프타지딤 등의 항생제를 즉시 투여합니다.
수술적 치료: 괴사 된 조직을 제거하는 변연절제술이나 심한 경우 절단술이 필요할 수 있습니다.
supportive care: 쇼크 치료, 수액 공급, 혈압 관리 등

예방법
바다 활동 시 주의사항
상처가 있을 때는 바다에 들어가지 마세요: 작은 상처라도 방수 밴드로 완전히 밀봉하거나 바다 활동을 피하는 것이 좋습니다.
보호장비 착용: 갯벌이나 어패류 손질 시 장갑과 장화를 반드시 착용하세요.
바다 활동 후 관리: 바다에서 나온 후 깨끗한 물로 상처 부위를 씻고 소독하세요.
어패류 섭취 시 주의사항
충분히 익혀 드세요: 어패류는 85도 이상에서 1분 이상 가열하여 섭취하세요.
날것 섭취 금지: 특히 고위험군은 생굴, 생새우, 생게 등을 절대 섭취하지 마세요.
신선한 어패류 선택: 구입 시 신선도를 확인하고 냉장 보관하세요.
응급 상황 대처법
다음과 같은 증상이 나타나면 즉시 응급실로 가세요:
- 바다 활동 후 갑작스러운 고열과 오한
- 상처 부위의 급속한 붓기와 발적
- 수포나 검은 반점 형성
- 구토, 설사와 함께 전신 쇠약감
기억하세요: 비브리오패혈증은 시간이 생명입니다. 의심 증상이 있으면 망설이지 말고 병원을 방문하세요.
통계와 현황
국내에서는 매년 7-10월 사이 주로 발생하며, 연간 40-60명의 환자가 신고됩니다. **치사율은 약 20-25%**로 매우 높은 편이며, 특히 기저질환자의 경우 더욱 높은 사망률을 보입니다.
최근 기후변화로 인한 해수온 상승으로 발생 시기가 길어지고 있어 더욱 주의가 필요한 상황입니다.
비브리오패혈증은 예방 가능한 질병입니다. 여름철 바다 활동 시 기본적인 예방 수칙만 지켜도 충분히 예방할 수 있습니다. 특히 기저질환이 있는 분들은 더욱 각별한 주의를 기울이시고, 의심 증상이 나타나면 즉시 의료진의 도움을 받으시기 바랍니다.
건강한 여름휴가와 건강한 가을 나들이를 위해 비브리오패혈증 예방 수칙을 반드시 기억해 주세요!
'Health' 카테고리의 다른 글
| 어린선(Ichthyosis) 완벽 가이드: 증상, 원인, 치료법 총정리 (0) | 2025.10.22 |
|---|---|
| 위말트 림프종: 위장에 발생하는 희귀 림프종에 대한 완전 가이드 (1) | 2025.09.19 |
| 전신홍반성낭창(루푸스) 완전가이드: 증상, 원인, 치료법 총정리 (2) | 2025.09.03 |
| 우리 아이 성조숙증, 언제 병원에 가야 할까요? (0) | 2025.08.20 |
| 저속노화의 비밀: 과학적으로 입증된 7가지 안티에이징 방법 (5) | 2025.08.01 |